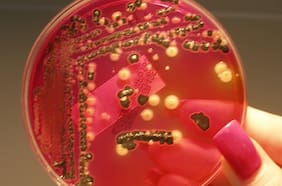
“Vampirismo bacteriano”: científicos descubren que muchas bacterias comunes se alimentan de sangre humana

E. coli
07 ENERO
05 AGOSTO
17 ABRIL
04 OCTUBRE
19 JUNIO
Juan Keymer, investigador del Núcleo Milenio Física de la Materia Activa (DFI-FCFM) estudia el comportamiento de colectivos de bacterias en mini laboratorios, en los que reproduce su nicho ecológico natural, para ver cómo compiten por él, para colonizarlo.
Científico chileno crea paisajes en un chip para estudiar cómo las bacterias colonizan los ecosistemas
14 SEPTIEMBRE
En un análisis de laboratorio a un grupo de celulares, encontramos todo tipo de bacterias: e.coli, que demuestra contaminación fecal, encontramos pseudomonas aeruginosa (que es extremadamente resistente a diferentes tipos de antibióticos), encontramos salmonela. Encontramos listeria...
Nuestros teléfonos móviles están cubiertos de bacterias y virus ... y nunca los lavamos
16 FEBRERO
16 FEBRERO
17 FEBRERO
16 FEBRERO
17 FEBRERO
Lo más leído
1.
2.
3.
5.
Plan digital + LT Beneficios por 3 meses
Cobertura completa, análisis y beneficios para todo el año 🔍🎁$3.990/mes SUSCRÍBETE